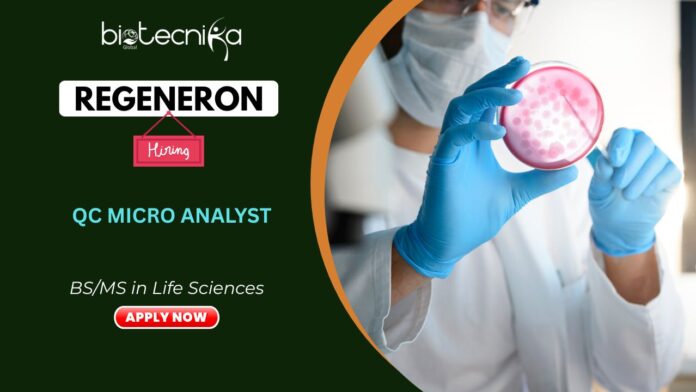

Microbiology Jobs at Regeneron: Apply Today & Discover QC Jobs
Regeneron, a world leader in biopharmaceutical innovation, as a Quality Control (QC) Microbiology Analyst and play a vital role in ensuring the safety and quality of life-changing therapies. In this position, you’ll conduct microbiological testing, environmental monitoring, and process validation to support the manufacturing of cutting-edge biologics. Regeneron empowers its employees through innovation, collaboration, and a mission-driven culture focused on improving patients’ lives worldwide.
Job Details:
- Position:Â Quality Control (QC) Microbiology Analyst
- Location:Â Rensselaer, New York, USA
About the Company:
Regeneron is a leading global biopharmaceutical company dedicated to manufacturing therapeutic proteins and biologics that improve the lives of patients worldwide. With a strong focus on science, innovation, and excellence, Regeneron produces approved therapeutic proteins and supports clinical studies that advance healthcare. The company’s inclusive culture, career development opportunities, and robust benefits make it a top destination for scientific professionals.
Microbiology Jobs at Regeneron- Role:
The Quality Control (QC) Microbiology Analyst plays a key role in ensuring the quality and safety of Regeneron’s biopharmaceutical products. Working Wednesday to Saturday from 1:00 pm to 11:30 pm, this position involves performing microbiological assays, environmental monitoring, and GMP-compliant testing in cleanroom and utility systems.
Microbiology Jobs at Regeneron- Key Responsibilities:
- Conduct environmental monitoring of controlled environments and utilities.
- Perform microbiological testing, including bioburden, endotoxin, growth promotion, and plate enumeration.
- Execute gowning and aseptic qualifications for personnel.
- Peer review data, draft SOPs, reports, documentation and risk assessments.
- Train employees and participate in continuous improvement initiatives.
- Support regulatory compliance through meticulous documentation and adherence to cGMP/FDA standards.
QC Jobs- Qualifications:
- Bachelor’s degree in Life Sciences or related field.
- For higher levels: 1–6+ years of relevant QC microbiology or GMP experience.
- Proficiency with Microsoft Office, LIMS, Deviation Management, and Learning Management Systems.
- Strong organizational and communication skills.
- Ability to multitask and thrive in a fast-paced, team-oriented environment.
Why Join Regeneron for QC Jobs:
At Regeneron, you’ll work in an inclusive, innovation-driven environment where scientific excellence meets purpose. The company offers competitive pay ($24.38–$43.80/hour), comprehensive health benefits, annual bonuses, equity awards, and paid time off. Employees are encouraged to learn, grow, and contribute to transformative therapies that shape the future of healthcare.